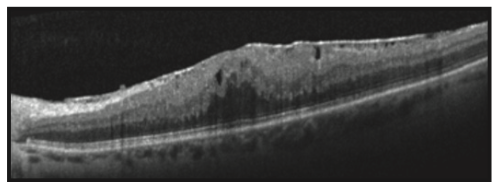
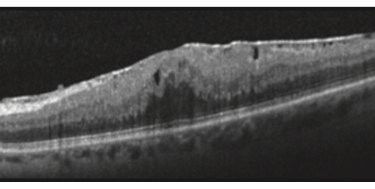

O que é Membrana Epirretiniana?
A membrana epirretiniana, também conhecida como pucker macular, é uma fina camada de tecido fibroso que se forma na superfície da retina, especificamente na mácula, que é a região responsável pela visão central e detalhada. Essa condição pode distorcer ou bloquear a visão central, causando dificuldades em atividades como leitura e reconhecimento de rostos.
Membrana Epirretiniana


Causas e Fatores de Risco
A membrana epirretiniana geralmente se desenvolve com o envelhecimento natural do olho. No entanto, outras condições podem aumentar o risco, como:
Descolamento do Vítreo Posterior: Uma condição comum em que o gel vítreo que preenche o olho se separa da retina.
Inflamação Ocular: Doenças inflamatórias como uveíte podem contribuir para a formação da membrana.
Traumas oculares ou cirurgias: Procedimentos cirúrgicos na retina ou traumas podem estimular o desenvolvimento da membrana.
Descolamento de Retina: Pacientes que passaram por descolamento de retina têm maior chance de desenvolver essa condição.
Sintomas
Os sintomas da membrana epirretiniana podem variar de leves a severos, e incluem:
Visão embaçada ou distorcida: As linhas retas podem parecer onduladas ou curvadas.
Diminuição da acuidade visual: Pode haver uma redução na capacidade de ver detalhes finos.
Diplopia monocular: Visão dupla pode ocorrer em um único olho.
Dificuldade em realizar tarefas que exigem visão detalhada: Como ler ou costurar.

Diagnóstico
O diagnóstico da membrana epirretiniana é realizado através de um exame oftalmológico completo, incluindo:
• Tomografia de Coerência Óptica (OCT): Um exame de imagem não invasivo que cria uma seção transversal detalhada da retina, permitindo visualizar a membrana e avaliar sua espessura e impacto na mácula.
Tratamento
Nem todas as membranas epirretinianas requerem tratamento imediato. Em casos onde a visão não é severamente afetada, o monitoramento regular pode ser recomendado. Entretanto, se a condição estiver prejudicando a qualidade de vida, a cirurgia pode ser considerada:
• Vitrectomia: É o procedimento cirúrgico mais comum para tratar a membrana epirretiniana. Durante a vitrectomia, o gel vítreo do olho é removido, e a membrana é cuidadosamente retirada da superfície da retina.
Prognóstico
A maioria dos pacientes experimenta uma melhora na visão após a cirurgia, embora a recuperação completa da acuidade visual original possa não ser possível em todos os casos. O tempo de recuperação varia, e a visão pode continuar a melhorar ao longo de meses após a cirurgia.
Visão
Cuidado personalizado para sua saúde ocular.
Clínica
Exames
+55 27 98111-6752
© 2024. All rights reserved.
+55 27 3336-5925
